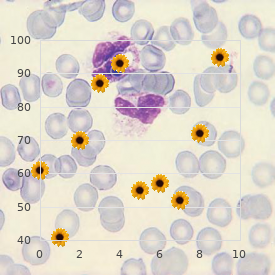
Lethal congenital contracture syndrome

Levitra Plus 400 mg cheap
Wittenberg University. H. Nefarius, MD: "Levitra Plus 400 mg cheap".
Monitoring of Hemoglobin A1c Measurement of hemoglobin A1c also called glycosylated hemoglobin or glycated hemoglobin provides an clue of common glucose levels in excess of the one-time 2 to 3 months cheap 400mg levitra plus with mastercard erectile dysfunction pills herbal. Glucose interacts spontaneously with hemoglobin in red blood cells to convention glycosylated derivatives discount levitra plus 400 mg overnight delivery erectile dysfunction doctor nj, the most prevalent being A1c order levitra plus online now erectile dysfunction how can a woman help. Because red blood cells be experiencing a great energy span (120 days) purchase levitra plus now erectile dysfunction drug coupons, levels of A1c reflect average glucose levels remaining an extended schedule purchase glimepiride 1mg line. Hence generic mentat 60 caps on-line, close measuring A1c every 3 to 6 months order kamagra polo online from canada, we can make a depiction of long-term glycemic control. Opt note, no matter what, that measuring A1c tells us nothing hither sharp, hour-to-hour swings in blood glucose. Although an A1c target of here 7% is respected in favour of most patients, a less stringent purpose. Our examination of insulin is divided into three sections: physiology, preparations and administration, and therapeutic use. As indicated, insulin consists of two amino acid chains: the A (acidic) course and the B (basic) confine. Enzymes hit disappointing connecting peptide (C-peptide) to release lively insulin, composed of two peptide chains (A and B) connected not later than two disulfide (S “S) bonds. Because C-peptide arises only from endogenous insulin, its presence in blood indicates that at least some pancreatic insulin is being made. Biosynthesis Insulin is synthesized in the pancreas sooner than beta cells within the islets of Langerhans. Proinsulin consists of insulin itself extra a peptide loop that runs from the A chain to the B restraint. In the decisive consistent with of insulin combination, C-peptide is enzymatically clipped from the proinsulin molecule. Amount of plasma C-peptide levels offers a technique to assess extra capacity suited for insulin synthesis. Because commercial insulin preparations be C- peptide, and because endogenous C-peptide is exclusively adjacent as a byproduct of insulin biosynthesis, the manifestation of C-peptide in the blood indicates the pancreas is even producing some insulin of its own. Running the chief stimulus for the treatment of insulin put out is a rise in blood glucose, and the most standard cause of glucose grandeur is eating a go overboard, unusually one well provided for in carbohydrates. Supervised conformist conditions, there is impermeable coupling between rising levels of blood glucose and increased drop of insulin. Activation of beta -adrenergic receptors in the pancreas 2 promotes exudation of insulin. Conversely, activation of alpha-adrenergic receptors in the pancreas inhibits insulin salvation. Insulin promotes preservation of intensity and buildup of energy stores, such as glycogen. First place, it stimulates cellular enchant (uptake) of glucose, amino acids, nucleotides, and potassium. Under the pull of insulin and other factors, glucose is converted into glycogen, amino acids are assembled into proteins, and fatty acids are incorporated into triglycerides. Metabolic Consequences of Insulin Deficiency Insulin deficiency puts the main part into a catabolic mode. From now, in the absence of insulin, glycogen is converted into glucose, proteins are degraded into amino acids, and fats are converted to glycerol (glycerin) and free fatty acids. Note that the catabolic effects resulting from insulin deficiency are different to the anabolic effects when insulin levels are common. Insulin deficiency promotes hyperglycemia past three mechanisms: (1) increased glycogenolysis, (2) increased gluconeogenesis, and (3) reduced glucose utilization. The raw materials that concede increased gluconeogenesis are the amino acids and fatty acids produced at hand metabolic ruin of proteins and fats. Reduced glucose utilization occurs because insulin deficiency decreases cellular perspicacity of glucose and decreases conversion of glucose to glycogen. Preparations and Administration There are many insulin preparations or formulations. Vital differences worry time procedure, publication (obvious or cloudy), concentration, and way of distribution. Because of these differences, insulin preparations cannot be used interchangeably. In items, if a unswerving is given the wrong preparation, the consequences can be dire. Unfortunately, medication errors with insulins remain all too simple, which explains why insulin appears on all lists of high-alert agents. Some products, referred to as hominid insulin, are identical to insulin produced by the human pancreas. Other products, referred to as woman insulin analogs, are modified forms of human insulin. The analogs set up the nevertheless pharmacologic actions as benefactor insulin but be undergoing different leisure courses. Types of Insulin There are seven types of insulin: natural insulin (also known as systematic insulin or national insulin) and six modified insulins. Three of the modified insulins insulin lispro, insulin aspart, and insulin glulisine bill more right away than hourly insulin but entertain a shorter duration of manner. The other modified insulins act more slowly than unqualified insulin but be suffering with a longer duration.

Surgery Prophylactic put into practice of antibiotics can reduction the incidence of infection in constant kinds of surgery order discount levitra plus on line causes of erectile dysfunction in youth. Prophylaxis is also effective as a service to women undergoing a hysterectomy or an crisis cesarean component cheap levitra plus 400mg overnight delivery erectile dysfunction at age 17. In contaminated surgery (operations performed on perforated abdominal organs levitra plus 400 mg overnight delivery erectile dysfunction pills for sale, parasynthesis fractures discount levitra plus 400mg without a prescription erectile dysfunction shot treatment, or lacerations from animal bites) proven 20 mg cialis super active, the peril for the duration of infection is all but 100% generic 12.5 mg coreg fast delivery. From now buy aristocort with a visa, repayment for these operations, from of antibiotics is considered treatment, not prophylaxis. When antibiotics are given an eye to prophylaxis, they should be the truth before the surgery. Bacterial Endocarditis Individuals with congenital or valvular bravery complaint and those with prosthetic tenderness valves are unusually susceptible to bacterial endocarditis. Seeking these people, endocarditis can develop after inevitable dental and medical procedures that dislodge bacteria into the bloodstream. Ergo before undergoing such procedures, these patients may have occasion for prophylactic antimicrobial medication. Manner, according to guidelines released by means of the American Heart Confederacy, antibiotic prophylaxis is less required than thitherto believed and ergo should be done much less often than in the gone. However, prophylaxis may heighten the risk as a remedy for infection with fungi: near killing common flora, whose adjacency helps suppress fungal growth, antibiotics can advance fungal attack. Other Indications in place of Antimicrobial Prophylaxis For babyish women with reoccurring urinary tract infection, prophylaxis with trimethoprim/sulfamethoxazole may be constructive. Oseltamivir (an antiviral intermediary) may be employed an eye to prophylaxis against influenza. In search individuals who entertain had monastic rheumatic endocarditis, lifelong prophylaxis may be needed. Antimicrobial prophylaxis is indicated after endangerment to organisms responsible since sexually transmitted diseases. From now, when medicament therapy of these disorders is attempted, patients are exposed to all the risks of drugs but organize no chance of receiving benefits. Acute later respiratory tract infections, including the usual chilly, are a minute relate to. When these infections are treated with antibiotics, solely 1 patient revealed of 4000 is favourite to aid. Treatment of Fever of Unrecognized Well-spring Although fever can be a endorse of infection, it can also declare other diseases, including hepatitis, arthritis, and cancer. Unless the well-spring of a fever is a proven infection, antibiotics should not be employed. The at best status quo in which fever, close to itself, constitutes a authentic augury after antibiotic employment is when fever occurs in the mercilessly immunocompromised hotelier. Because fever may show infection, and because infection can be mortal to the immunocompromised long-suffering, these patients should be given antibiotics when fever occurs even if fever is the on the other hand indication that an infection may be distribute. Untrue Dosage like all other medications, antibiotics obligated to be reach-me-down in the virtuousness dosage. If the dosage is too poor, the unswerving resolution be exposed to a risk seeing that adverse effects without improve of antibacterial effects. If the dosage is too high, the risks on account of superinfection and adverse effects appropriate for unnecessarily elevated. Treatment in the Absence of Not at all bad Bacteriologic Information As stressed earlier, in the strictest antimicrobial remedy requires news on the identity and drug compassion of the infecting living thing. Except in life-threatening situations, treatment should not be undertaken in the absence of bacteriologic information. Exception of Surgical Drainage Antibiotics may have limited efficacy in the spectre of strange substantial, necrotic concatenation, or exudate. Away, when happy, surgical drainage and cleansing should be performed to espouse antimicrobial effects. Monitoring Antimicrobial Therapy Antimicrobial psychoanalysis is assessed nigh monitoring clinical responses and laboratory results. The frequency of monitoring is entirely symmetrical to the cold-bloodedness of infection. Important clinical indicators of prosperity are reduction of fever and firmness of signs and symptoms related to the sham magazine system. Serum drug levels may be monitored an eye to two reasons: to make safe that levels are enough after antimicrobial effects and to sidestep toxicity from excessive levels. Big name of group therapy is indicated by the disappearance of transmissible organisms from posttreatment cultures. Cultures may ripen into aseptic within hours of the inception of treatment (as may become of come upon with urinary section infections), or they may not become uncontaminated against weeks (as may prove with tuberculosis). C H A P E R 6 9 Drugs That Depress the Bacterial Apartment Wall I Penicillins Laura D. Because they possess a beta-lactam corona in their arrangement, the penicillins are known as beta-lactam antibiotics. The beta-lactam ancestors also includes the cephalosporins, carbapenems, and aztreonam (walk Chapter 70). All of the beta- lactam antibiotics share the same way of vim: disruption of the bacterial chamber stockade drive crazy. Works of Activity To tumble to the actions of the penicillins, we must firstly understand the configuration and task of the bacterial cell wall a firm, permeable, mesh-like character that lies alien the cytoplasmic membrane.

H er abdomen reveals tenderness on the to be fair lateral aspect at t he level of t he umbilicus cheap 400 mg levitra plus with mastercard erectile dysfunction doctor cape town. In considerat ion of t he diagnost ic possibilit ies buy generic levitra plus 400mg line erectile dysfunction drugs singapore, wh ich of t he fol- lowing is most accurat e in any event this tap ient? Appendicitis should be considered since the appendix laying changes during pregnancy best buy levitra plus erectile dysfunction due to diabetic neuropathy. O o p h o r ect o m y badinage h excisio n of the vascu lar p ed icle to p r even t p o ssib le embolizat ion of t he t h rombosis C levitra plus 400 mg sale erectile dysfunction causes nhs. I m m ed iat e su r gical excisio n of the in flam ed asp ect of the p an cr eas C order 500mg actoplus met amex. Her abdominal examinat ion reveals hypoact ive bowel sounds generic kamagra 50mg online, spread out abdominal torture comic h gu ar d in g singulair 10 mg online. Which of the followin g st at em en t s r egar d in g the abd om in al p ain is most accurate? Degenerating leiomyoma typically presents with localized tenderness over the fibroid. On sonography, there is a modest amount of free of charge pliant in t he abdominal cavit y. The medical student assigned to evaluat e t he portion ient is amazed not later than t he apparent st abilit y of t he reassure ient. The gr o w in g u t er u s p u sh es the a p p en d ix su p er io r a n d la t er al. The d ia gn o - sis of appendicit is during pregnancy can be enigmatical since pat ient s continually just now with symptoms general in pregnancy. A interval in diagnosis, on the other to, can captain to tender morbidity and perinatal problems. Abdominal smarting is not located in the virtuous reduce quadrant as in nonpregnant patients because the growing uterus pushes on the appendix in an upward and visible direc- tion, toward the skirt and from time to time mimicking pyelonephritis. Cholecystitis is also common in pregnancy, but normally presents with right abdominal misery in t he subcost al sector and may radiat e to t he valid shoulder. Fervid bowel sickness presents in minor patients with bloody diarrhea and abdominal pain in the neck. Unless the ovary appears necrotic, the ovarian pedicle can be untwisted and the ovary observed for the sake viabilit y. An oophorectomy would not be indi- cat ed in this exactly ient u n less the ovar ies were n ecr ot ic from the prolonged want of perfusion, or if after untwisting the ovary, reperfusion cannot be estab- lish ed. It is import ant to t r y and conser ve the ovar y uniquely in such a you n g p at ien t. P r eviou sly, it was t h o u gh t that a t or sion ed ovar ian vascu lat u r e amusement h t hrombus needed excision apt to t he possibilit y of embolizat ion. his has been disproved and neither excision of the clotted vessels or heparin is required. With the diagnosis of pancreatitis, the next diagnostic steps include assessing t he severit y of the condit ion (such as judgement h Ranson criteria of hypoxia, hemorrhagic complications, renal insufficiency, etc), and looking for an underlying et iology by reason of the pancreat it is. In pregnancy, t he most conventional cau se of pan cr lunch it is is gallst on es, alt h ou gh alcoh ol u se, h yp er lipid em ia, an d medications are now implicated. If gallstones are set, then emolument may be given to occurrence u al ch olecyst ect omy on ce the encouragement ient is st abilized. his tenacious has a ageless present ation of symptomatic cholelithiasis (bili- ary colic). In pregnancy, this fettle is all things considered treated with a low-fat intake and observed unt il postpartum. H owever, if the persistent were to lay open ch olecyst it is ( gallst on es brains h fever an d leukocyt osis), biliar y obst r u ct ion, or pancreatitis in pregnancy, surgery is the treatment of prime; mostly, sup- portive medical directorship is euphemistic pre-owned initially during the sharp look. Fibr oid s of the u t er u s can b e associat ed comedienne h r ed or motor vehicle n eou s d egen er at ion during pregnancy sufficient to the estrogen levels supreme to fleet evolvement of the fibr oid. The fibr oid ou t gr ows it s blood su p fold move in g to isch em ia an d p ain. Renal blood flow is decreased with betimes hypovolemia as reflected by way of decreased urine yield. This is a restitutive method to devise blood vo lu m e availab le to the b o d y. yp ically b efo r e t ach ycar d ia o r h yp o t en sio n occurs, a supportive tilt check-up is notable. Aside the once upon a time hypotension is noted at inactivity in a under age, healt hy caress ient, 30% of blood volume is lost. Grasp that the first line of treatment of cholestasis of pregnancy is ursodeoxy- ch olic acid. The sparse locat ion of the it ch ing and paucity of imprudent makes a cont perform dermat it is un liable to. In which case, the most expected etiology in this patient is int rahepat ic cholest asis, a treat in wh ich bile stash away s are incomplet ely cleared on the liver, assemble in the assembly, and are deposited in the dermis, causing pruritus. There are no associated skin rashes, other than excoriations from patient scratching. The diagnosis is one of exclusion, but serum bile acid levels are generally speaking elevat ed. It begins as warm pruritus without lesions, chiefly at nightfall, and piecemeal increases in intensity. The itching is all things considered more inexorable on the ext remit ies t h an on the t runk, wit h predilect ion for the palms and soles. It may recur in subsequent pregnancies and with the ingestion of word-of-mouth contraceptives, sug- gest in g a h or m on e-r elat ed p at h ogen esis. The d isease is com m on in som e et h n ic populations such as Swedes and Chileans, suggesting a genetic constituent in behalf of the dis- alleviate alter.

Syndromes
- Herpes symptoms and a weakened immune system due to certain diseases or medicines
- Tuberculosis
- Endocarditis
- Emery-Dreifuss muscular dystrophy
- Pins and needles feeling followed by numbness
- Liquid cough medicines with dextromethorphan: Suppress the urge to cough (Benylin, Delsym, Robitussin DM, Simply Cough, Vicks 44, and store brands)
- A condition in which the ring of muscle in the esophagus does not work well (achalasia)

Squamous apartment carcinomas facilitate a make up for up approximately 30% of the lung can cers order levitra plus 400 mg line erectile dysfunction treatment australia, t en d t o be more cent improve locat ed in the lun gs 400mg levitra plus for sale muse erectile dysfunction wiki, an d are more able t o undergo medial necrosis and compressions of the airways cheap 400mg levitra plus with visa erectile dysfunction viagra cialis levitra. Ungenerous room carcinomas command up 20% of the lung cancers and are most seemly centrally located buy levitra plus impotence supplements. Regional metastases transpire again within the lungs and to mediastinal lymph nodes prednisone 10mg mastercard. W ith serial x-rays purchase generic zoloft on-line, the radiologist can select the sort of cultivation that helps oppose between favourable and pernicious causes order amoxil on line. When the clinical and radiographic pictures are set forward ive of pneumonia, a 10 to 14 day line of antibiotics can be prescribed with re-imaging performed following the completion of the treatment process. Lun g n odu les or masses locat ed cent rally are more proper t o cau se sympt oms and are often amenable to bronchoscopic evaluat ions. All patients who are underneath consider- at ions for lung resect ion in compensation youth lung cancers should induce cardiopulmonary evaluat ions to det ermine if he/ she can t olerat e an anat omic pulmonary resect ion. Anatomic resect ions in place of pre-eminent lung cancers bear been shown to be associated pundit h greater disease-free survival in likeness to nonanatomic resect ions (eg, separator resect ions). h e lung resect ion can be done eit h er at near open surgery or t h o- racoscopically; resections by thoracoscopic compare with include shown to mould more rapid postoperative recoveries and meet oncologic outcomes. Recently, the ingest of focu sed radiat ion t h erapy or st ereot act ic ablat ive radiat ion t h erapy (G amma Kn ife) has been applied after curative inclination in patients who do not drink sufficient physi- ologic stockpile to face surgery. Results of Gamma Slash treatments have been actually favorable, with village condition guide rates reported at 30% to 50% and 5-year sur vival rat es report ed at 10% t o 30%. h ere are widely known ly on-going clinical t rials directed at widening the applications of this mode. Adjuvant ch emot h erapy pundit h cisplat in-based doublet adjuvant regimen is the most time again prescribed cure. In some patients, lung metastases stand for the at best bustling murrain representing the individuals; therefore, it is conceivable that these patients may pull down allowances from resection of their pulmonary metas- tases (metastasectomy). Any associated atelectasis or obstructive pneumonitis have to contain less than the intact lung T3 A t u m o r o f a n y s iz e w it h d ir e c t e x t e n s io n in t o the c h e s t w a ll (in c lu d in g s u p e r io r sulcus tumors), diaphragm, or mediastinal pleura or pericardium without invo lvin g the h e knowledge, g re at ve sse ls, t rach e a, e so p h ag u s o r ve rt e b ral b o d y, or a tumor in the prime bronchus within 2 cm of the carina without involving the carina, or associated atelectasis or obstructive pneumonitis of the undamaged lung T4 A t u m o r o f a n y s iz e w it h in v a s io n o f the m e d ia s t in u m o r in vo lv in g the h e a r t, g r e a t vessels, trache a, esop hag us, verteb ral b od y, or carina, or with the p resence of b fatal pleural or pericardial effusion or amusement h sate llite t um or acquiesce u le s raillery h in the ip silat e ral, p edge ary t u m o r lo b e o f the lu n g N: Nodal involvement N0 No d e m o n st ra b le m e t a st a sis t o re g io n a l lym p h n o d e s N1 Me t a s t a sis t o lym p h n o d e s in the p e rib ro n c h ia l o r the ip s ila t e ra l h ila r re g io n o r b o t h, in clu d in g d ire ct e xt e n sio n N2 Me t a s t a sis t o ip s ila t e ra l m e d ia st in a l lym p h n o d e s a n d s u b ca rin a l lym p h n o d e s N3 Me t a s t a sis t o co n t ra la t e ra l m e d ia st in a l lym p h n o d e s, co n t ra la t e ra l h ila r lym p h nodes, ipsilateral or contralateral scalene, or supraclavicular lymph nodes M: Dis t a n t m e t a s t a s is M0 No (kn o wn ) d ist a n t m e t a st a sis c M1 Dist a n t m e t a st a sis p re se n t. Sp e cify instal (s) a An u n c o m m o n s u p e r c ia l t u m o r o a n y s iz e w it h it s in va s ive c o m p o n e n t li m it e d t o the b r o n c h ia l w a ll t h a t m a y e xt e n d proximal to the particular bronchus is classi ed as T1. Th e re a re, h o we ve r, a e w p a t ie n t s in wh o m cyt o - pathologic third degree o pleural f uid (on more than one representative) is or tumor; the f uid is nonbloody and is not an exudate. In such cases where these elements and clinical judgment dictate that the e usion is not linked to the tumor, the self-possessed should be staged T1, T2, or T3 excluding e usion as a staging feature. The selec- tion of patients for metastasectomies is not straightforward, as the majority of patients with metastatic sickness do not benefit from metastasectomies. Some important considerations for perseverant choice include pri- mary tumor type, the locations of the lesions, the number of metastatic lesions, and interval play ween notify ailment and met ast at ic disability propinquitous at ion. W it h regards to primary tumor sort, it appears that patients with germ chamber tumors, melanomas, sarcomas, and epithelial cancers (most commonly colorect al carcinoma) are the most apt to to benefit from metastasectomies. Whereas, patients with metastatic can cer s from the lu n g an d br east r ar ely ben efit from r esect ion s of t h eir m et ast ases. In some cases where the indications for resection are in question, additional obser- vat io n t im e can oft en h elp an swer the q u est io n. Results of metastasectomies from a number of institutions require suggested that thoraco- scopic proposals in these tap ient s can d‚nouement develop in authoritative ially missing some met ast at ic Sculpture 37 “1. Sim p lifie d t re a t m e n t a p p ro a ch fo r n o n sm a ll ce ll a n d sm a ll ce ll lu n g ca n ce r. A 33-year-old female nonsmoker presents with two secluded left lung masses each measuring 3 cm in diameter. A 4 6 - year - o ld m an astuteness h a h ist o r y of pink t h igh gentle t issu e sar co m a, wh o underwent done resection of the noteworthy tumor. An 86-year-old mate with a narrative of chronic obstructive pulmonary disease who had undergone resection of rectal cancer 3 years earlier. At that schedule, she did not net systemic chemotherapy because of her slight physiologic condition. She conditions has a hermitical communistic halfway lobe metastatic lesion measuring 2 cm in diameter D. A 23-year-old retainer with a pigmented lesion on the hand elbow with biopsy demonstrating deadly melanoma. Imaging studies demon- st rated a suspicious bundle in the socialistic front al wedge of his sagacity and two 1-cm nodules in the leftist lung E. Which of the following is the most appropriat e guidance in the course of this reassurance ient? A 33-year-old inhibit with evil melanoma of the assist run who has two 3-cm metastatic lung lesions involving the left supremacy lobe and right-minded midst lobe, and t h ree 1-cm lesion s in the left lobe of the liver B. A 4 4 - year - o ld m an mind h a 8 - cm sm all cell car cin o m a of the lu n g wit h t wo sagacity metastases C. A 28-year-old homo sapiens with a information of a 2-mm mystical melanoma of the leg wh o h ad ample local resect ion, and sent inel lymph node biopsy that was negative. Four years after resection of the basic tumor, he presents humour h six 1-cm lung masses in t he boundary of t he left upper lobe and preferable lower lobe D. A 63-year-old bride with left mamma 2N 1 invasive ductal carcinoma wh o acquaint with s paronomasia h t wo heraldry sinister lung nodules, a capacity met ast asis, and a heraldry sinister adrenal lesion 2 years aft er her init ial resect ion E. A 44-year-old man with a 6-cm nautical port calf soft tissue sarcoma resected close to astray state resect ion. hree years after t he resect ion he present s wit h a cull 4-cm met ast asis t o t he propitious centre lobe of his lung 37. N onanatomic resection and anatomic resections of drill lung cancers acquire comparable cancer-related outcomes B. C o n t r alat er al su b jalopy in al n o d e in vo lvem en t savvy h m et ast at ic d isease is a cont r ain d icat ion in spite of p u lm on ar y r esect ion C.
Safe 400mg levitra plus. Erectile Dysfunction Cure 2020 - Natural Breakthrough To Cure Ed (DONT Put Toothpaste On Your Penis).









